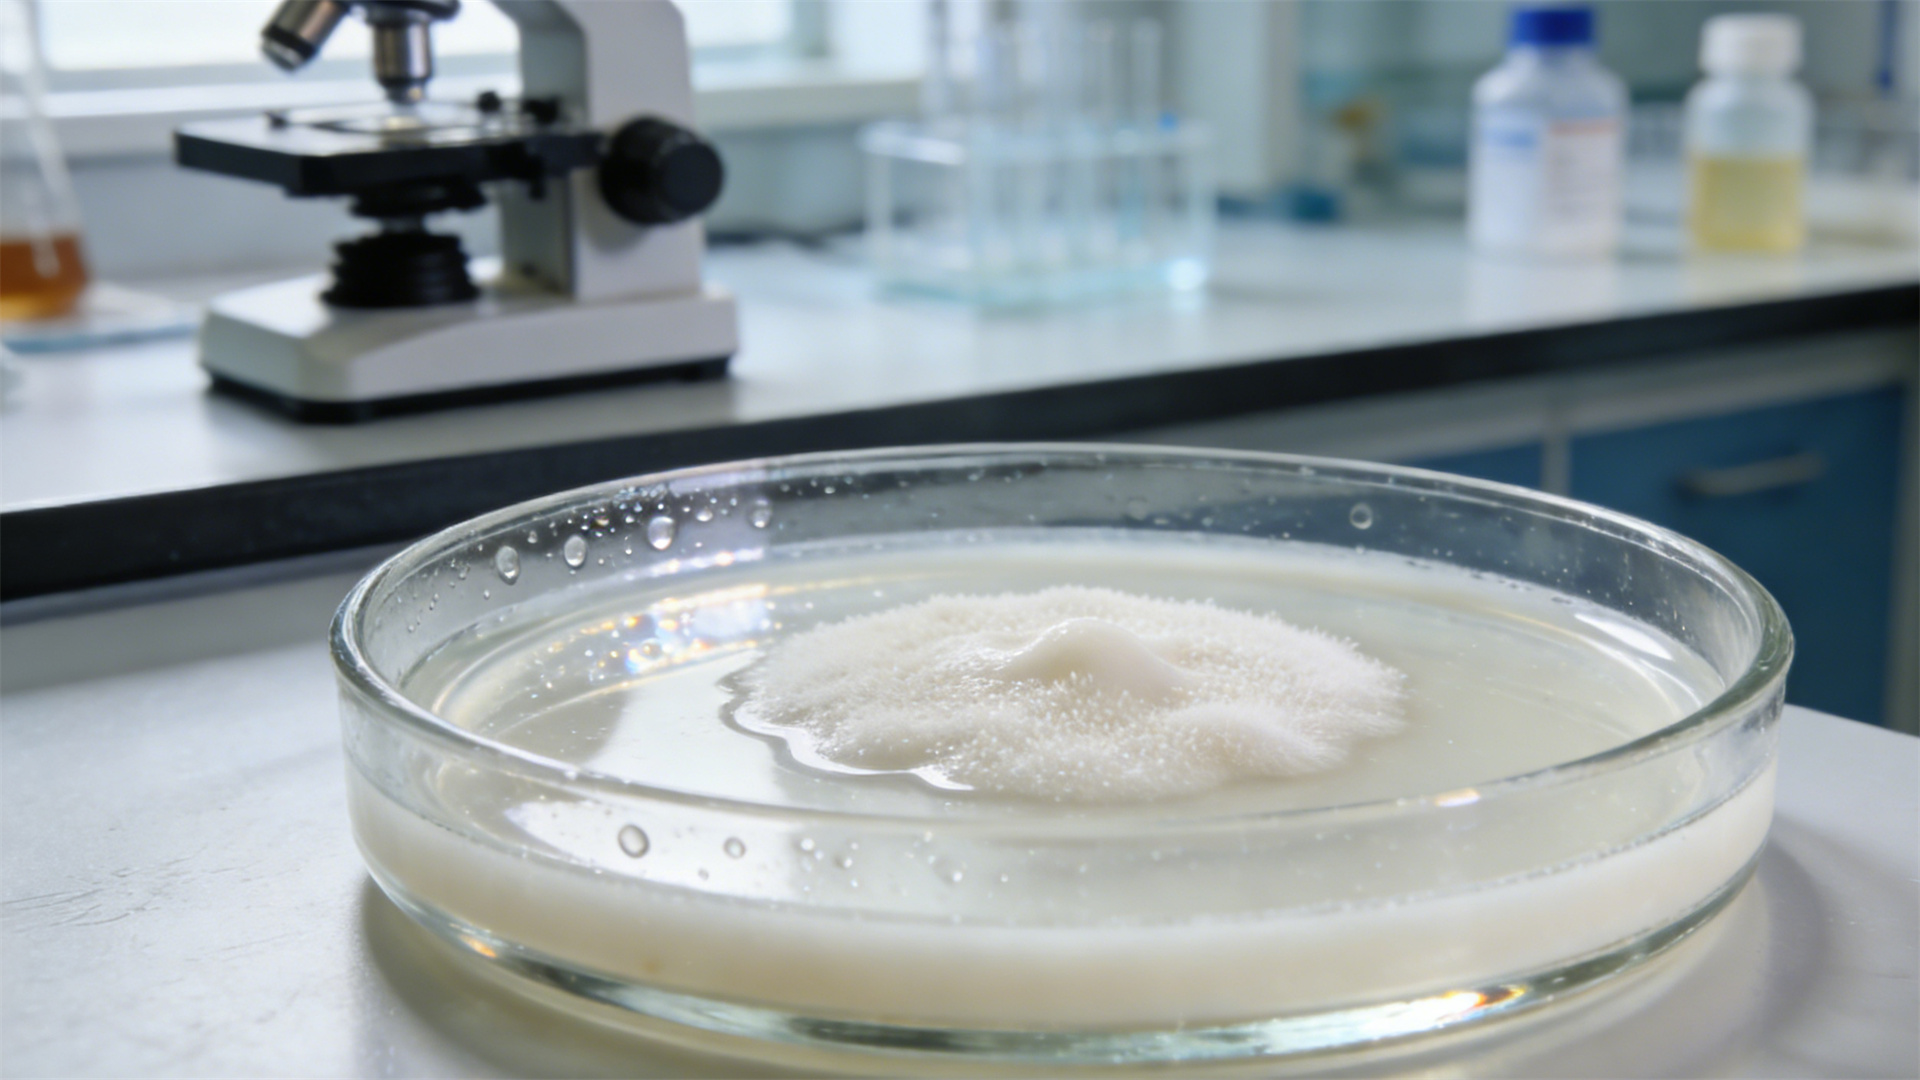
Functional Snack Review: Besides being good for teething, can they really be absorbed through the bloodstream?

If you're a dog owner, you know the drill. Your puppy is chewing everything in sight, or your adult dog's breath could clear a room. You reach for a dental chew. For years, these treats have been marketed and accepted for their mechanical benefits: scrubbing away tartar, massaging gums, and keeping a teething pup occupied. This is common knowledge. But walk down the pet aisle today, and you'll see a new generation of snacks. These aren't just "dental chews"; they're functional dog treats infused with probiotics, omega-3s, glucosamine, and even chlorophyll, promising benefits from calmer moods to healthier joints and improved gut health. This raises a compelling, less-understood question: Can these bioactive ingredients actually be absorbed through the bloodstream to deliver systemic health benefits, or is this just clever marketing wrapped in a chew? In this comprehensive review, we will investigate the science behind the mechanisms, separate proven facts from hopeful claims, and provide you with a clear-eyed evaluation of these popular products.

🦷 The Foundation: Teething and Mechanical Cleaning
Before we dive into the complex world of bioavailable functional snacks for dogs, let's establish the baseline. Traditional and functional dental chews share a core mechanical principle. Their unique textures, ridges, and knobs are designed to scrape against the tooth's surface as the dog gnaws, physically disrupting plaque before it mineralizes into tartar. The act of chewing also stimulates saliva production, which has natural enzymatic properties that help wash away food particles and bacteria. For puppies, the pressure on sore gums provides welcome teething relief, and the appropriate chewiness helps guide adult teeth in correctly. This physical action is undeniable and provides a tangible, immediate benefit. It is the "what you see" part of the equation. The new promise of systemic health dog chews, however, is all about the "what you don't see"—the internal, whole-body effects.
🔬 The Active Ingredients Deep Dive
This is where the rubber meets the road. To understand if absorption through the bloodstream in dog treats is possible, we must examine the common additives and their biological pathways. Not all ingredients are created equal, and their journey from chew to cell varies dramatically.
Probiotics and Digestive Enzymes
These are live beneficial bacteria and proteins meant to support gut health. The Critical Question: Can they be absorbed through the gums? The simple answer is no. Probiotics are not absorbed into the bloodstream through oral tissues. Their target is the gastrointestinal tract. To be effective, they must survive the chew process, be swallowed, and then survive the harsh, acidic environment of the stomach to colonize the intestines. The viability of probiotics in a shelf-stable chew is a major point of scrutiny. Reputable brands use hardy, spore-forming strains and conduct stability testing to ensure live microbes are present at the point of consumption. The bioavailability here is gut-based, not bloodstream-based, but a healthy gut can positively impact systemic health.
Omega-3 Fatty Acids (EPA/DHA)
Typically derived from fish oil, algae, or flaxseed, these are famed for supporting skin, coat, joint, and cognitive health. Absorption Pathway: Omega-3s are lipids (fats). They are not significantly absorbed in the mouth. The primary site of absorption is the small intestine. Once digested, they are incorporated into chylomicrons and enter the lymphatic system before eventually reaching the bloodstream. The key for a chew is whether the omega-3 source is protected from oxidation (rancidity) during the manufacturing process and storage. A rancid fat loses its benefit and can be harmful. Studies on omega-3 supplementation in dogs are robust, but they typically use oils or capsules, not chews. The efficacy in a chew format depends entirely on the quality and stability of the ingredient.
Glucosamine and Chondroitin
The classic joint support duo. These are large molecules meant to provide building blocks for cartilage. Absorption Pathway: Like omega-3s, these are not absorbed through the oral mucosa. They must be digested. Glucosamine is a small enough molecule to be absorbed reasonably well in the intestines, while chondroitin is larger and its bioavailability in dogs is debated, though veterinary studies often show a positive clinical effect for the combination. The evidence for their efficacy in managing osteoarthritis in dogs is stronger than for many other supplements, but again, the research is based on powdered or pill forms in specific, often high, doses. Whether a chew contains a clinically effective dose is a vital consideration.
Chlorophyll and Herbal Extracts
Often marketed for "internal deodorizing" or calming. Chlorophyllin (a semi-synthetic form) can bind to certain odor-causing compounds in the gut. Herbs like chamomile or valerian are claimed to have calming effects. Absorption Pathway: These compounds generally require gastrointestinal digestion and absorption. The idea of chlorophyll being absorbed through the gums to purify blood is not supported by canine physiology. Any systemic effect would follow the standard swallow-digest-absorb route. The concentration and standardization of herbal extracts in pet treats are also rarely disclosed, making their true effect difficult to assess.

✅ The Absorption Question Answered
So, can the ingredients in functional dog treats be absorbed through the bloodstream? The answer is nuanced but clear.
Direct Absorption Through Gums (Transmucosal): For the vast majority of functional additives—probiotics, enzymes, omega-3s, glucosamine, herbs—meaningful, systemic absorption does not occur through the gum tissue. The oral mucosa is excellent for absorbing certain small molecules like nitroglycerin (a drug), but it is not a primary route for the nutrients and compounds found in these chews. Marketing that suggests ingredients "enter directly into the bloodstream" for immediate effect is, at best, misleading regarding the pathway.
Systemic Benefits via Digestion (The Real Route): This is the correct and still valuable pathway. The dog chews and swallows the treat. Ingredients are digested in the stomach and intestines, where they are broken down and absorbed into the bloodstream via the portal circulation or lymphatic system. From there, they are distributed to target tissues. Therefore, the true questions of efficacy become: one, does the chew contain a bioavailable form of the ingredient? two, is the ingredient present in a stable and effective dose? and three, is there peer-reviewed veterinary science supporting its use for the claimed benefit?
Evidence varies widely. For instance, the joint health benefits of glucosamine/chondroitin sulfate have more clinical backing in dogs than the "calming" effect of unspecified chamomile in a chew. Always look for references to specific studies, ideally conducted on dogs and published in journals like the Journal of the American Veterinary Medical Association.

📊 Review Framework: Evaluating Popular Brands
Let's apply this knowledge to a review of two popular brands in the functional dental space. Our criteria focus on ingredient credibility, dose transparency, and the realism of absorption claims.
Brand A: "Gut-Health & Dental" Probiotic Chews
Claimed Benefits: Reduces tartar, supports digestion, boosts immunity via probiotics.
Ingredient Deep Dive: Lists specific probiotic strain names (e.g., Bacillus coagulans), which is a good sign. This strain is known for survival in harsh conditions.
Absorption Claim Credibility: Brand claims "supports gut health directly." They correctly focus on the gut as the target, not the bloodstream, which is accurate.
Texture & Palatability: Firm, nubbed texture good for dental scraping. Highly palatable per user reviews.
Verdict: A credible option for dog dental health with a tangible added functional benefit, provided the probiotics are viable at feeding time.
Brand B: "Advanced Joint & Mobility" Dental Sticks
Claimed Benefits: Cleans teeth, supports joints with glucosamine and MSM.
Ingredient Deep Dive: Lists "glucosamine hydrochloride" and "MSM" but no disclosed amounts. A typical joint supplement for a medium dog might provide 500-1000mg of glucosamine daily; a single chew likely contains far less.
Absorption Claim Credibility: Makes no outlandish claims about direct absorption. The systemic benefit is implied via digestion, which is correct.
Texture & Palatability: Excellent dental texture. Dogs love them.
Verdict: A fine dental chew that may provide a supplementary dose of joint support ingredients. However, for a dog with diagnosed arthritis, it should not replace a therapeutic-dose veterinary supplement. It's a "bonus," not a treatment.

💡 Practical Takeaways for Dog Owners
Navigating the world of functional pet snacks requires a savvy eye. Here is your actionable guide.
How to Read Labels: Look past the front package. The ingredient panel is key. Seek out specific, named ingredients (e.g., "krill oil," "Lactobacillus acidophilus," "green-lipped mussel extract") over vague terms ("omega blend," "digestive support formula"). Check if the guaranteed analysis or supplement facts panel lists amounts of active ingredients.
When They Are a Good Choice: These treats are an excellent supplemental choice for the health-conscious owner wanting to add variety and potential extra benefits to their dog's regimen. They are particularly useful as a dual-purpose product: addressing dental hygiene while potentially supporting a specific area like gut or joint health, especially in maintenance or early support stages.
Special Reminder: Functional dental chews are not a substitute for three critical things: a complete and balanced primary diet, professional veterinary care (including dental cleanings), and a proper diagnosis for any health condition. Never use a functional chew to treat a medical issue without veterinary guidance.

🎯 Conclusion: The Final Verdict
So, can the ingredients in functional dental snacks be absorbed through the bloodstream for systemic benefits? The definitive answer is yes, but not in the way you might think.
The pathway is almost never direct absorption through the gums. Instead, the beneficial ingredients are swallowed, digested, and then absorbed through the standard gastrointestinal route to enter the bloodstream and exert their effects. Therefore, the bloodstream absorption of pet supplements from a chew is real, but it's an indirect process dependent on quality, dose, and bioavailability.
The value proposition of these treats is solid when viewed realistically. They offer a convenient, often highly palatable, two-in-one solution: mechanical dental cleaning plus supplemental nutrition. Your takeaway should be cautious optimism. Choose brands that are transparent about their ingredients and sourcing, manage your expectations regarding the dose provided per chew, and always prioritize a high-quality main diet. When selected wisely, a functional dog dental chew can be a valuable tool in your holistic pet care toolkit—just don't expect it to be a magic bullet that bypasses biology.






